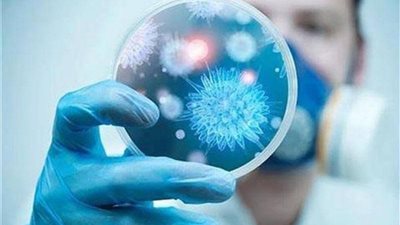

عاجل
أيمن الرقب: جولة نتنياهو بسوريا محاولة انتخابية لفرض وهم الانتصار والترويج لتطبيع مزعوم مع دولة عربية
هل يضم الجيش السوداني عناصر إخوانية؟ خبير عسكري يُجيب(فيديو)
أيمن الرقب لـ "الفجر": ولي العهد وضع الكرة في ملعب إسرائيل… ولا تطبيع بلا التزام واضح بمسار حل الدولتين
أحمد السقا لنزار الفارس: «أنا عمري ما رفعت يدي على واحدة ست… قاموسي لازم أمشي عليه»
أحمد السقا لنزار الفارس: «أنا دائرة علاقاتي صغيرة لكن كل مصر أصحابي… أنا مش ملاك»